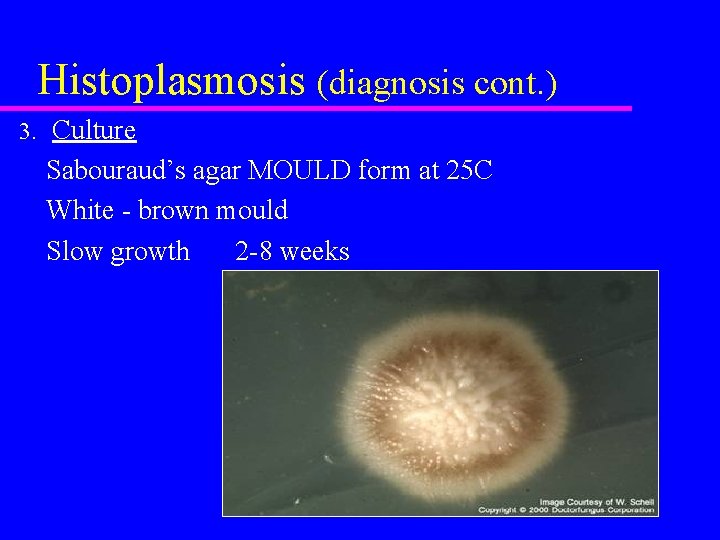
Histoplasmosis (diagnosis cont. ) 3. Culture Sabouraud’s agar MOULD form at 25 C White

DIMORPHIC FUNGI Part 1 Dr Hams M A

- Slides: 34
DIMORPHIC FUNGI Part 1 Dr. Hams M. A. Mohamed
Endemic systemic mycoses dimorphic fungi Geographic variation in incidence – Histoplasma capsulatum – Blastomyces dermatitidis – Coccidioides imitis – Paracoccidioides brasiliensis – Penicillium marneffei Other dimorphic – Sporothrix schenckii
HISTOPLASMOSIS Pathogenesis Respiratory Infections inhale spores macrophages in lung yeast form macrophases ingest yeast Lymph nodes Liver Spleen Adrenal glands Intestine Bone Marrow Proliferation halted by onset of acquired CMI at 10 -14 d. Vasculitis, tissue necrosis, caseating granulomata. Killing by macrophages, healing, calcification
Histoplasmosis Clinical u. Caused by: Histoplasma capsulatum » Pulmonary disease (coough, dysnea, anaroxia, abortion) then disseminated » Infect dogs, cats , equines, man
Epizootic lymphangitis u Caused by: histoplasma farciminosum u Host: equines u Contagious lymphangitis infected muscle characterized by nodular lesion on skin , lymphytic vessele of legs , neck , nasal passage u Transmitted through insects bites u Epizootic lymphangitis differntiated from glanders by mallien test
u Mallein and serological tests: The mallein test is a sensitive and specific clinical test for hypersensitivity against Burkholderia mallei. Mallein, a water soluble protein fraction of the organism, is injected subcutaneously, intradermo-palpebrally or given by eyedrop. In infected animals, the skin or the eyelid swells markedly within 1– 2 days. u +ve result swelling and redness in eye lids
African HISTOPLASMOSIS u. CAUSE: H. duboisii u. Infect equines u. Infection in lymph node and bone marrow
Oral histoplasmosis
Histoplasmosis Chronic fibrocavitary histoplasmosis Histoplasmoma
Histoplasmosis Diagnosis 1. Obtain appropriate specimens sputum bone marrow blood lesion scrapings urine biopsy specimens 2. Direct Examination u Tissue Specimens – stains for fungi - PAS, GMS, Giemsa – routine histology - H & E, calcofluor - small yeast (2 -4 ) at 37 C budding cell intracellular in macrophages or from tissue In culture at 25 C : Macroconidia larg sun flower like Microconidia tear drop like
GMS lung biopsy At 25 C At 37 C
Calcofluor stain x 400 Narrow-neck bud Wet mount at 37 C
Histoplasmosis (diagnosis cont. ) 3. Culture Sabouraud’s agar MOULD form at 25 C White - brown mould Slow growth 2 -8 weeks
Sabouraud’s agar YEAST form at 37 C SMOOTH and white in color
Diagnosis (cont. ) u 4. Serology – Complement fixation test (CFT) – -Elisa – 5 -Exoantigen test – Soluble antigen extracted from culture identified by immunodiffusion test against different antibodies
Exoantigen test
Allergic test u. A technician cleans your forearm with an antiseptic agent, such as an alcohol swab. Then, injects a small amount of an allergen(histoplasmin) under skin. u Results: u +ve The skin surrounding the injection site may become itchy, irritated, red, or inflamed if you have tested positive.
Histoplasmosis treatment 1. Immunocompetent (acute pulmonary, u Mild – none u Moderate - Itraconazole 200 mg p. O OD x 9 mo or increased oral dose until response or IV u Severe - IV amphotericin B 2. u localized, disseminated, including meningitis) Immunocompromised Moderate to severe – Ampho B IV (total 10 -15 mg/kg) or liposomal AMB – Itraconazole suppressive 200 mg OD u Less severe – Itraconazole 300 mg p. O BIDx 3 d, then 200 p. O BID x 12 wk, then 200 mg p. O OD
BLASTOMYCOSIS Dimorphic Has sexual stage – Ajellomyces dermatitidis Not intracellular infection Mainly N. America (also S. America, Africa, Mid-East) N. America Mississippi, Missouri and Ohio Great Lakes and St. Lawrence River Exposure to soil risk of infection Warm, moist soil of wooded areas Rich in organic debris Hard to isolate from environmental sources
Blastomycosis Pathogenesis Blastomyces dermatitidis Primary pulmonary infection Dissemination Broad clinical manifestations Especially bone, skin, lung, genito-urinary system Chronic granulomatous and suppurative infection lung inhale conidia (spores) mycelial phase in soil yeast phase conversion Inflammatory response Neutrophilic Non-caseating granulomas Pyo-granulomatous response Epithelioid & giant cells
Blastomycosis Pathogenesis u Primary pulmonary infection – Conidia phagocytosed by neutrophils, but not killed. Macrophages may kill conidia – Condia germinate into yeast forms in lung, grow and disseminate via bloodstream » Bone, skin and genito-urinary system – pyogranulomatous response (neutrophils and macrophages) » Non-caseating granulomata
Blastomycosis fungal disease infect dogs, man charcterized by granulomatous and suppurative nodules with caseating necrosis that begin in lung and disseminate to internal organs reach to corneal opacity and orchitis
Blastomycosis Clinical 1. Acute Flu-like symptoms (fever, muscle pain, joint pain, chills, chest pain, cough) Pneumonia Spontaneous resolution is rare Most patients go on to chronic or recurrent infection CXR – lower lobe consolidation
Blastomycosis Clinical 2. Chronic/Recurrent – Pulmonary - chronic pneumonia - cavitation - pleural involvement – Skin 40 -80% skin and mucosa - pustular (verrucous), heaped-up - ulcerated lesions – Subcutaneous nodules – Bone/joint infection – GU tract - prostate, epididymis
Blastomycosis - skin
Blastomycosis Lobar pneumonia Verrucous knee lesion
BLASTOMYCOSIS DIAGNOSIS 1. Direct Examination at 37 C: double countered thick wall and cytoplasmic grnulation Sputum Prostatic fluid Pus (skin, etc. ) Urine Biopsy In culture: oval pear shape conidia - KOH, calcofluor - yeast - PAS, GMS, H & E
Gram stain At 37 C At 25 C
Tissue stains Skin biopsy PAS Brain biopsy PAS
BLASTOMYCOSIS DIAGNOSIS (cont. ) 2. Culture - slow growth ~ 14 days up to 8 weeks - Mycelial form at 250 C white to light brown u yeast form at 370 C: WAXY, wrinkled, creamy color
BLASTOMYCOSIS DIAGNOSIS (cont. ) - SEROLOGY u Complement Fixation Test (CFT) u Immunodiffusion u ELISA
BLASTOMYCOSIS TREATMENT Treat all active cases 1. Itraconazole (200 -400 mg OD x 6 months) Except CNS blastomycosis 2. Amphotericin B IV (x 6 -10 weeks) Life-threatening disease CNS disease